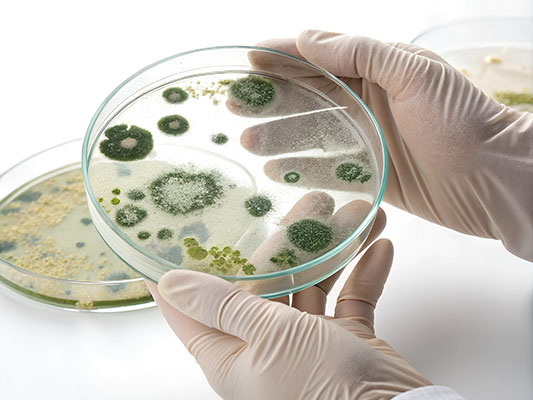
schimmelpilzanalyse

Hier finden Sie einen Auszug aus dem Untersuchungsprogramm:
- Probenentnahmen als Abklatsch, Klebe, Material und Raumluftproben
- Untersuchung / Schimmel- Differenzierung von Raumluftproben
- Schimmel- Differenzierung Abklatsch- und Klebeproben
- Materialproben / Direktmikroskopie zur Untersuchung auf Schimmel
- Auswertung von Klebe- und Abklatschproben (Tesa- Präparaten)
- Auswertung von Sammelspuren nicht kultivierbarer Raumluftbestandteile
- Bewertung der Proben
- Raumklimamessungen
- Erstellen von Sanierungskonzepten und Gefährdungsabschätzungen
Wir bieten Ihnen kurze Bearbeitungszeiten.